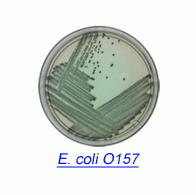
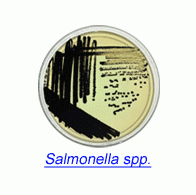
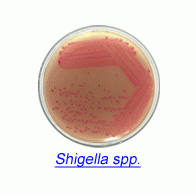

Analytical Product

| BAX® System Q7 |
| PCR 병원균 테스트 |
| Hygiena International |
다운로드 
| BAX® System SalQuant |
| 살모넬라 PCR 정량 분석 |
| Hygiena International |

| BAX® System X5 |
| PCR 병원균 테스트 |
| Hygiena International |
다운로드 
| foodproof® Salmonella plus Cronobacter Detection LyoKit |
| PCR Kit for Infant Formula, Raw Materials, Production Environments |
| Hygiena International |

| foodproof® 맥주 변질/부패 세균 스크리닝 PCR 키트 |
| PCR Kit for Beer Screening |
| Hygiena International |

| RiboPrinter® System |
| 미생물 동정, 특성화, 오염원 추적 |
| Hygiena International |
다운로드 
| Lateral Flow System |
| Salmonella, Listeria, E.coli O157 스크리닝 |
| Hygiena International |
다운로드 
| Innovate System (AOAC 인증) |
| 신속 미생물 스크리닝 시스템 |
| Hygiena International |
다운로드
| Rainbow® Agar O157 |
| Chromogenic Media for Microbial Detection |
| Biolog |
다운로드
| Rainbow® Agar Salmonella |
| Chromogenic Media for Microbial Detection |
| Biolog |
다운로드
| Rainbow® Agar Shigella/Aeromonas |
| Chromogenic Media for Microbial Detection |
| Biolog |
다운로드 
| CrossCheck |
| Acid Phosphatase Test |
| Hygiena International |
다운로드 
| ZymoSnap ALP |
| Alkaline Phosphatase Test [AOAC 인증] |
| Hygiena International |
다운로드 
| O157 and non-O157 STEC Antibodies |
| STEC 항체 |
| ABRAXIS |
다운로드 
| E. coli Latex Agglutination Tests & IMS Beads |
| ABRAXIS |
다운로드 
| Shiga Toxin 1 ELISA Kits |
| 장출혈성 대장균 ELISA 키트 |
| ABRAXIS |
다운로드 
| Shiga Toxin 2 ELISA Kits |
| 장출혈성 대장균 ELISA 키트 |
| ABRAXIS |
다운로드
1
